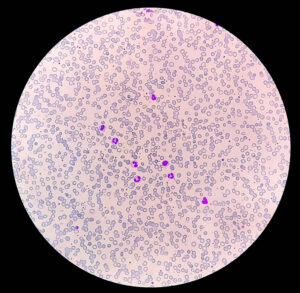
Severe Anemia Case Study
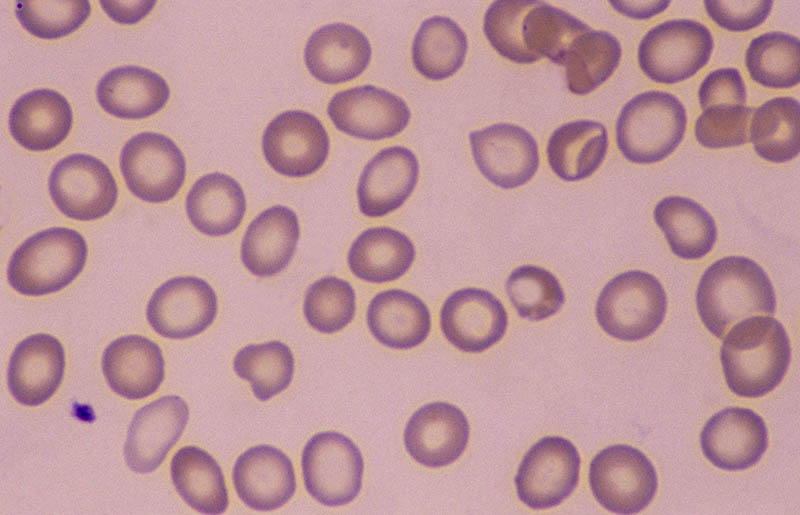
Severe Iron deficiency anemia
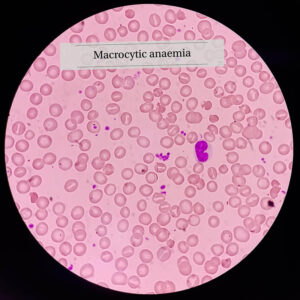
macrocytic aneimia folic acid vitB12 def
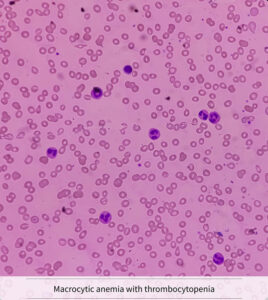
macrocytic anemia with thrombocytopenia
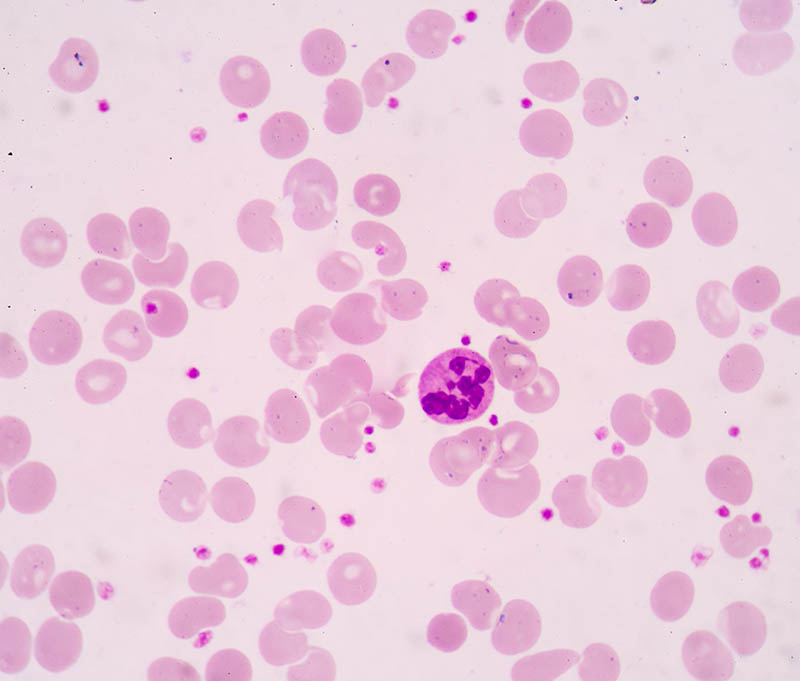
hypersegmented neutrophils.2

Severe Anemia Case Study: Lab Interpretation Guide for Accurate Diagnosis
Introduction to Severe Anemia Case Study (Step-by-Step Lab Interpretation)
Understanding Severe Anemia: Definition and Clinical Significance
What Is Anemia?
When Does Anemia Become Severe?
Case Presentation: Patient History and Symptoms
Demographic Information
Presenting Complaints
Physical Examination Findings
Step 1: Complete Blood Count (CBC) Interpretation
Hemoglobin and Hematocrit Analysis
Red Blood Cell Indices (MCV, MCH, MCHC)
Microcytic, hypochromic anemia strongly suggests:
Red Cell Distribution Width (RDW)
Step 2: Peripheral Blood Smear Evaluation

Morphological Abnormalities
Diagnostic Clues from Cell Shape
Step 3: Reticulocyte Count and Bone Marrow Response
Step 4: Iron Studies Interpretation
Serum Ferritin
Serum Iron and TIBC
Transferrin Saturation
Step 5: Vitamin B12 and Folate Testing

Step 6: Additional Investigations
Differential Diagnosis of Severe Anemia
Final Diagnosis and Clinical Reasoning
Treatment Plan and Follow-Up Strategy
Immediate Management
Long-Term Plan
Complications of Untreated Severe Anemia
Preventive Strategies
Frequently Asked Questions (FAQs)
1. What is the first test to order in suspected severe anemia?
2. Why is ferritin important?
3. Can severe anemia be life-threatening?
4. How quickly does iron therapy work?
5. When is transfusion required?
6. What causes microcytic anemia?
This Severe Anemia Case Study (Step-by-Step Lab Interpretation) illustrates how systematic laboratory interpretation leads to accurate diagnosis. By analyzing CBC indices, peripheral smear findings, reticulocyte count, and iron studies, we identified iron deficiency as the root cause.Understanding this step-by-step method ensures safe clinical decision-making and improved patient outcomes.
